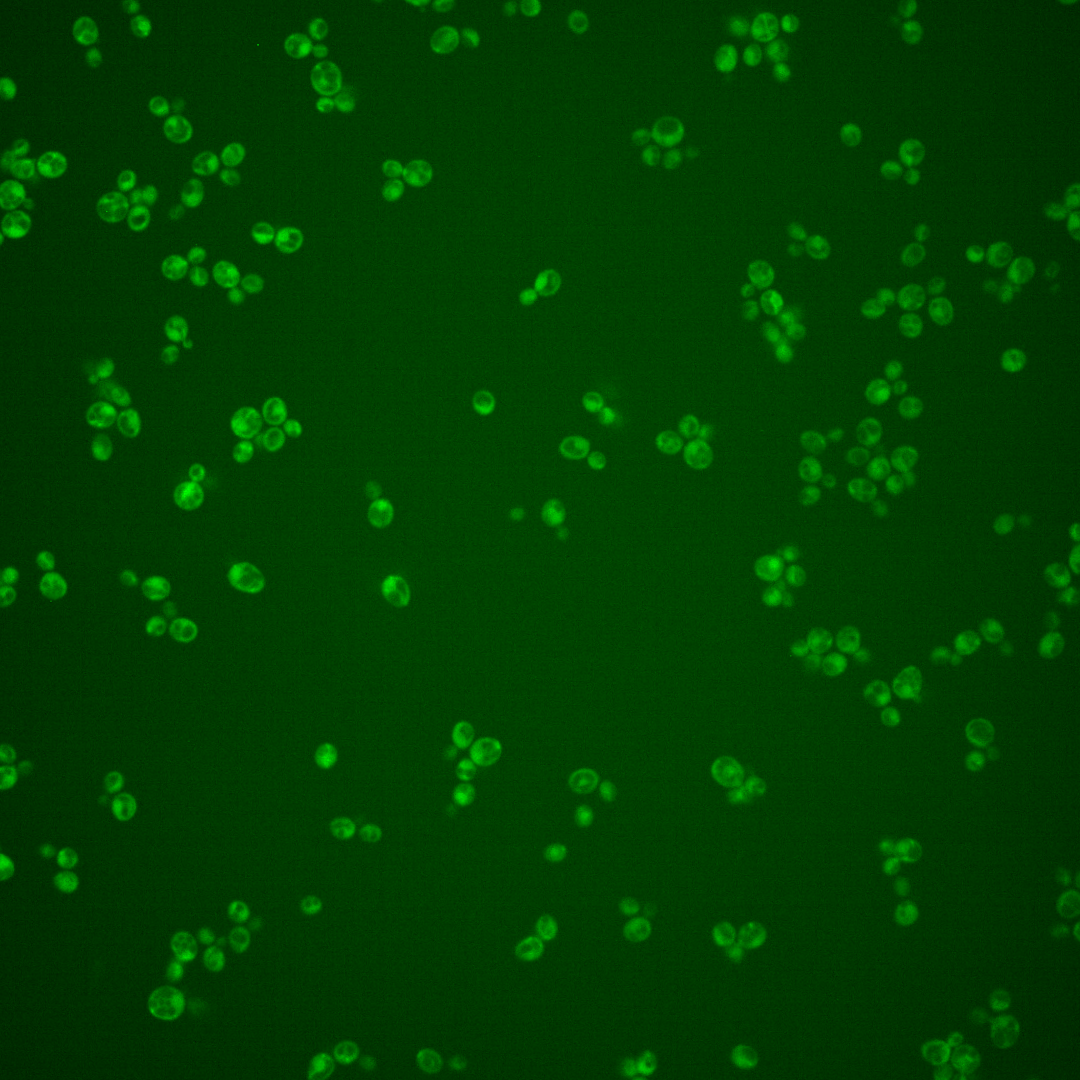

| Standard name | |
|---|---|
| Human Ortholog | |
| Description | High-affinity S-adenosylmethionine permease; required for utilization of S-adenosylmethionine as a sulfur source; has similarity to S-methylmethionine permease Mmp1p |
Micrographs




















































































Sub-cellular Localization
Yeast GFP Assignment
Protein Abundance
Localization Change
External localization resources
| ensLOC | DeepLoc | |||||||||||||||||||||||
|---|---|---|---|---|---|---|---|---|---|---|---|---|---|---|---|---|---|---|---|---|---|---|---|---|
| Localization | WT1 | WT2 | WT3 | RAP60 | RAP140 | RAP220 | RAP300 | RAP380 | RAP460 | RAP540 | RAP620 | RAP700 | HU80 | HU120 | HU160 | rpd3Δ_1 | rpd3Δ_2 | rpd3Δ_3 | WT1 | WT2 | WT3 | AF100 | AF140 | AF180 |
| Cortical Patches | 1 | 1 | 3 | 1 | 0 | 1 | 2 | 2 | – | 0 | 2 | 5 | 0 | 0 | 0 | 11 | 5 | 2 | 4 | 5 | 4 | 1 | 2 | 4 |
| Bud | 0 | 0 | 2 | 0 | 1 | 3 | 5 | 7 | – | 12 | 12 | 17 | 0 | 0 | 0 | 0 | 3 | 0 | 4 | 5 | 6 | 1 | 0 | 2 |
| Bud Neck | 2 | 0 | 0 | 0 | 0 | 0 | 0 | 1 | – | 0 | 0 | 1 | 2 | 2 | 2 | 0 | 0 | 0 | 3 | 3 | 2 | 0 | 0 | 2 |
| Bud Site | 0 | 0 | 0 | 0 | 0 | 1 | 0 | 2 | – | 2 | 0 | 3 | 0 | 0 | 0 | 0 | 0 | 0 | – | – | – | – | – | – |
| Cell Periphery | 1 | 0 | 4 | 2 | 2 | 2 | 3 | 6 | – | 6 | 7 | 16 | 8 | 6 | 5 | 37 | 12 | 6 | 1 | 1 | 3 | 1 | 0 | 1 |
| Cytoplasm | 255 | 205 | 201 | 185 | 215 | 183 | 222 | 242 | – | 150 | 120 | 126 | 417 | 351 | 449 | 28 | 29 | 18 | 197 | 157 | 95 | 66 | 115 | 139 |
| Endoplasmic Reticulum | 7 | 14 | 10 | 11 | 22 | 13 | 18 | 12 | – | 20 | 20 | 39 | 5 | 5 | 7 | 1 | 0 | 2 | 18 | 28 | 56 | 4 | 3 | 6 |
| Endosome | 1 | 0 | 3 | 0 | 1 | 2 | 2 | 7 | – | 2 | 0 | 3 | 2 | 0 | 1 | 0 | 1 | 0 | 3 | 1 | 3 | 1 | 1 | 4 |
| Golgi | 1 | 0 | 0 | 0 | 0 | 0 | 0 | 0 | – | 0 | 0 | 0 | 0 | 0 | 1 | 7 | 7 | 10 | 0 | 1 | 0 | 0 | 2 | 3 |
| Mitochondria | 10 | 9 | 14 | 22 | 14 | 103 | 165 | 225 | – | 216 | 174 | 204 | 0 | 1 | 0 | 11 | 2 | 3 | 29 | 13 | 47 | 10 | 15 | 13 |
| Nucleus | 0 | 0 | 0 | 0 | 0 | 3 | 2 | 4 | – | 1 | 5 | 2 | 0 | 0 | 1 | 2 | 0 | 0 | 0 | 0 | 0 | 0 | 0 | 0 |
| Nuclear Periphery | 0 | 0 | 1 | 0 | 0 | 1 | 3 | 4 | – | 3 | 2 | 13 | 0 | 0 | 0 | 3 | 1 | 1 | 0 | 0 | 0 | 0 | 0 | 2 |
| Nucleolus | 1 | 0 | 2 | 0 | 1 | 1 | 0 | 0 | – | 0 | 0 | 1 | 0 | 0 | 0 | 0 | 0 | 0 | 0 | 0 | 0 | 0 | 0 | 0 |
| Peroxisomes | 0 | 0 | 0 | 0 | 0 | 0 | 0 | 0 | – | 0 | 0 | 1 | 0 | 0 | 0 | 0 | 0 | 0 | 0 | 0 | 0 | 0 | 0 | 0 |
| SpindlePole | 0 | 0 | 0 | 0 | 0 | 1 | 0 | 3 | – | 3 | 0 | 6 | 0 | 0 | 0 | 1 | 0 | 0 | 1 | 4 | 4 | 1 | 1 | 3 |
| Vac/Vac Membrane | 0 | 2 | 5 | 5 | 8 | 11 | 9 | 41 | – | 24 | 24 | 40 | 0 | 0 | 1 | 12 | 18 | 3 | 5 | 7 | 5 | 2 | 4 | 3 |
| Unique Cell Count | 271 | 223 | 225 | 207 | 257 | 261 | 345 | 446 | 336 | 283 | 351 | 425 | 357 | 458 | 105 | 70 | 41 | 278 | 234 | 237 | 94 | 151 | 193 | |
| Labelled Cell Count | 279 | 231 | 245 | 226 | 264 | 325 | 431 | 556 | 439 | 366 | 477 | 434 | 365 | 467 | 113 | 78 | 45 | 278 | 234 | 237 | 94 | 151 | 193 | |
Yeast GFP Assignment
Protein Abundance
| Screen | WT1 | WT2 | WT3 | RAP60 | RAP140 | RAP220 | RAP300 | RAP380 | RAP460 | RAP540 | RAP620 | RAP700 | HU80 | HU120 | HU160 | rpd3Δ_1 | rpd3Δ_2 | rpd3Δ_3 | AF100 | AF140 | AF180 |
|---|---|---|---|---|---|---|---|---|---|---|---|---|---|---|---|---|---|---|---|---|---|
| Mean Cell GFP Intensity (1e-4) | 4.0 | 4.8 | 4.5 | 4.0 | 4.8 | 3.8 | 4.1 | 4.0 | – | 3.7 | 4.2 | 4.8 | 4.9 | 5.0 | 5.2 | 14.0 | 14.3 | 19.3 | 5.4 | 5.5 | 6.2 |
| Std Deviation (1e-4) | 1.1 | 2.4 | 2.7 | 1.8 | 3.9 | 2.0 | 3.0 | 1.8 | – | 2.0 | 2.4 | 2.4 | 0.8 | 1.0 | 1.1 | 3.3 | 3.9 | 4.8 | 3.4 | 2.0 | 3.5 |
| Intensity Change (Log2) | – | – | – | -0.18 | 0.09 | -0.24 | -0.14 | -0.18 | – | -0.28 | -0.12 | 0.08 | 0.13 | 0.15 | 0.19 | 1.63 | 1.66 | 2.09 | 0.27 | 0.28 | 0.46 |
Localization Change
| Localization | RAP60 | RAP140 | RAP220 | RAP300 | RAP380 | RAP460 | RAP540 | RAP620 | RAP700 | HU80 | HU120 | HU160 | rpd3Δ_1 | rpd3Δ_2 | rpd3Δ_3 |
|---|---|---|---|---|---|---|---|---|---|---|---|---|---|---|---|
| Actin | – | – | – | – | – | – | – | – | – | – | – | – | – | – | – |
| Bud | – | – | – | – | – | – | – | – | – | – | – | – | 0 | 0 | – |
| Bud Neck | – | – | – | – | – | – | – | – | – | – | – | – | 0 | 0 | – |
| Bud Site | – | – | – | – | – | – | – | – | – | – | – | – | 0 | 0 | – |
| Cell Periphery | – | – | – | – | – | – | – | – | – | – | – | – | 0 | 0 | – |
| Cyto | – | – | – | – | – | – | – | – | – | – | – | – | – | – | – |
| Endoplasmic Reticulum | – | – | – | – | – | – | – | – | – | – | – | – | 0 | 0 | – |
| Endosome | – | – | – | – | – | – | – | – | – | – | – | – | 0 | 0 | – |
| Golgi | – | – | – | – | – | – | – | – | – | – | – | – | 0 | 0 | – |
| Mitochondria | – | – | – | – | – | – | – | – | – | – | – | – | 0 | 0 | – |
| Nuclear Periphery | – | – | – | – | – | – | – | – | – | – | – | – | 0 | 0 | – |
| Nuc | – | – | – | – | – | – | – | – | – | – | – | – | – | – | – |
| Nucleolus | – | – | – | – | – | – | – | – | – | – | – | – | 0 | 0 | – |
| Peroxisomes | – | – | – | – | – | – | – | – | – | – | – | – | 0 | 0 | – |
| SpindlePole | – | – | – | – | – | – | – | – | – | – | – | – | 0 | 0 | – |
| Vac | – | – | – | – | – | – | – | – | – | – | – | – | – | – | – |
| Cortical Patches | – | – | – | – | – | – | – | – | – | – | – | – | 0 | 0 | – |
| Cytoplasm | – | – | – | – | – | – | – | – | – | – | – | – | 0 | 0 | – |
| Nucleus | – | – | – | – | – | – | – | – | – | – | – | – | 0 | 0 | – |
| Vacuole | – | – | – | – | – | – | – | – | – | – | – | – | 3.5 | 6.4 | – |
External localization resources
Images






























Protein Concentration and Protein Localization Data
| R1 | R2 | R3 | ||||||||||||||||
|---|---|---|---|---|---|---|---|---|---|---|---|---|---|---|---|---|---|---|
| G1 Pre-START | G1 Post-START | S/G2 | Metaphase | Anaphase | Telophase | G1 Pre-START | G1 Post-START | S/G2 | Metaphase | Anaphase | Telophase | G1 Pre-START | G1 Post-START | S/G2 | Metaphase | Anaphase | Telophase | |
| Concentration | 4.6369 | 3.6208 | 4.17 | 3.3021 | 5.329 | 3.6298 | 3.1225 | 4.9294 | 4.6026 | 4.0057 | 3.6538 | 4.8936 | 2.0924 | 6.3688 | 4.5463 | 4.4179 | 2.7705 | 3.4018 |
| Actin | 0.0041 | 0.0028 | 0.0143 | 0.0007 | 0.0021 | 0.0029 | 0.0088 | 0.0033 | 0.0043 | 0.001 | 0.0136 | 0.0015 | 0.0001 | 0.0015 | 0.0615 | 0.001 | 0.0001 | 0.0011 |
| Bud | 0.0006 | 0.0109 | 0.0018 | 0.0011 | 0.0006 | 0.0008 | 0.0008 | 0.0067 | 0.0012 | 0.0012 | 0.0013 | 0.001 | 0 | 0.001 | 0 | 0 | 0 | 0.0001 |
| Bud Neck | 0.0003 | 0.0006 | 0.0004 | 0.0009 | 0.0014 | 0.0013 | 0.0003 | 0.0003 | 0.0013 | 0.0001 | 0.0006 | 0.0006 | 0 | 0.0001 | 0.0001 | 0.0001 | 0.0001 | 0.001 |
| Bud Periphery | 0.0015 | 0.0135 | 0.0025 | 0.0035 | 0.0058 | 0.0023 | 0.003 | 0.0096 | 0.0032 | 0.0033 | 0.0023 | 0.0073 | 0 | 0.0014 | 0 | 0.0001 | 0 | 0.0003 |
| Bud Site | 0.0003 | 0.0262 | 0.0015 | 0.0007 | 0.0005 | 0.0004 | 0.0017 | 0.0095 | 0.0049 | 0.0002 | 0.0008 | 0 | 0 | 0.0012 | 0.0002 | 0.0001 | 0 | 0 |
| Cell Periphery | 0.0007 | 0.0017 | 0.0009 | 0.0004 | 0.0018 | 0.0007 | 0.0039 | 0.0034 | 0.0023 | 0.0009 | 0.0012 | 0.0015 | 0.0003 | 0.0011 | 0.0004 | 0.0004 | 0.0001 | 0.0002 |
| Cytoplasm | 0.2491 | 0.3589 | 0.2321 | 0.3213 | 0.342 | 0.3647 | 0.3012 | 0.3046 | 0.2576 | 0.2355 | 0.3578 | 0.286 | 0.2539 | 0.266 | 0.2394 | 0.3535 | 0.3411 | 0.4359 |
| Cytoplasmic Foci | 0.0129 | 0.0212 | 0.0244 | 0.0244 | 0.0054 | 0.011 | 0.0143 | 0.0108 | 0.0176 | 0.0071 | 0.0106 | 0.0114 | 0.0006 | 0.0037 | 0.0069 | 0.0016 | 0.0018 | 0.0081 |
| Eisosomes | 0.0002 | 0.0001 | 0.0003 | 0.0001 | 0.0003 | 0.0001 | 0.0002 | 0.0001 | 0.0003 | 0.0001 | 0.0003 | 0.0001 | 0 | 0.0001 | 0.0001 | 0 | 0 | 0 |
| Endoplasmic Reticulum | 0.3985 | 0.2114 | 0.3592 | 0.2356 | 0.4664 | 0.2925 | 0.294 | 0.2507 | 0.3333 | 0.3291 | 0.2502 | 0.3306 | 0.3972 | 0.383 | 0.4332 | 0.2133 | 0.0036 | 0.1922 |
| Endosome | 0.0393 | 0.0366 | 0.0283 | 0.0316 | 0.0219 | 0.0125 | 0.0132 | 0.0201 | 0.0235 | 0.008 | 0.0256 | 0.0239 | 0.0024 | 0.0122 | 0.0141 | 0.0012 | 0.0003 | 0.0053 |
| Golgi | 0.0047 | 0.0022 | 0.0037 | 0.0023 | 0.0017 | 0.0005 | 0.0021 | 0.0064 | 0.0032 | 0.0005 | 0.0107 | 0.002 | 0.0001 | 0.0006 | 0.0008 | 0.0003 | 0 | 0.0003 |
| Lipid Particles | 0.012 | 0.0167 | 0.0074 | 0.0022 | 0.0071 | 0.0021 | 0.0086 | 0.005 | 0.0076 | 0.0016 | 0.0172 | 0.006 | 0.0006 | 0.0016 | 0.0042 | 0.0003 | 0.0001 | 0.0007 |
| Mitochondria | 0.0023 | 0.0009 | 0.0104 | 0.0045 | 0.0015 | 0.0007 | 0.0017 | 0.0005 | 0.0014 | 0.0008 | 0.0232 | 0.0014 | 0.0001 | 0.0005 | 0.0002 | 0.0001 | 0 | 0.0004 |
| None | 0.2058 | 0.2451 | 0.2676 | 0.3444 | 0.1099 | 0.252 | 0.3105 | 0.3375 | 0.2861 | 0.3627 | 0.2165 | 0.3059 | 0.3303 | 0.2348 | 0.2302 | 0.4232 | 0.6511 | 0.3378 |
| Nuclear Periphery | 0.0435 | 0.0254 | 0.0285 | 0.0083 | 0.0139 | 0.0301 | 0.0112 | 0.0128 | 0.0189 | 0.0175 | 0.0417 | 0.0116 | 0.012 | 0.0722 | 0.005 | 0.0025 | 0.0004 | 0.0092 |
| Nucleolus | 0.0002 | 0.0007 | 0.0003 | 0.0003 | 0.0001 | 0.0003 | 0.0003 | 0.0007 | 0.0029 | 0.0004 | 0.0004 | 0.0001 | 0 | 0.0003 | 0 | 0 | 0 | 0 |
| Nucleus | 0.0105 | 0.0094 | 0.0057 | 0.0036 | 0.0061 | 0.0121 | 0.0032 | 0.0054 | 0.0058 | 0.0062 | 0.005 | 0.0032 | 0.0005 | 0.0035 | 0.0007 | 0.0012 | 0.0006 | 0.0021 |
| Peroxisomes | 0.0003 | 0.0003 | 0.0009 | 0.0006 | 0.0001 | 0.0002 | 0.004 | 0.0001 | 0.007 | 0.0002 | 0.0035 | 0.0003 | 0 | 0.0001 | 0.0006 | 0 | 0 | 0.0001 |
| Punctate Nuclear | 0.0013 | 0.0044 | 0.0025 | 0.0023 | 0.0008 | 0.005 | 0.0058 | 0.0015 | 0.0047 | 0.001 | 0.0015 | 0.0005 | 0 | 0.001 | 0.0004 | 0.0001 | 0.0002 | 0.0005 |
| Vacuole | 0.0095 | 0.0095 | 0.0056 | 0.0088 | 0.0094 | 0.0065 | 0.01 | 0.0097 | 0.011 | 0.0187 | 0.0074 | 0.0041 | 0.0014 | 0.0099 | 0.0018 | 0.0008 | 0.0002 | 0.0031 |
| Vacuole Periphery | 0.0023 | 0.0014 | 0.0016 | 0.0022 | 0.001 | 0.0013 | 0.0011 | 0.0014 | 0.0019 | 0.004 | 0.0085 | 0.0009 | 0.0002 | 0.004 | 0.0002 | 0.0001 | 0 | 0.0015 |
Sequencing Data
| R1 | R2 | |||||||||
|---|---|---|---|---|---|---|---|---|---|---|
| G1 Post-START | S/G2 | Metaphase | Anaphase | Telophase | G1 Post-START | S/G2 | Metaphase | Anaphase | Telophase | |
| Gene Expression | 56.6089 | 36.9052 | 90.8693 | 111.9159 | 51.0933 | 44.3868 | 40.5658 | 52.8503 | 78.181 | 45.7594 |
| Translational Efficiency | 0.9808 | 1.1239 | 0.9164 | 0.9771 | 0.9448 | 1.2 | 0.908 | 0.8093 | 0.777 | 0.7526 |
Hit Data
| Dataset | Hit |
|---|---|
| Protein Concentration | ✘ |
| Protein Localization | ✘ |
| Gene Expression | ✘ |
| Translational Efficiency | ✘ |
Endocytosis
| Temp | Actin Patch (Sac6-tdTomato) | Cortical Patch (Sla1-GFP) | Late Endosome (Snf7-GFP) | Vacuole (Vph1-GFP) |
|---|---|---|---|---|
| 37℃ | ||||
| RT |
Cell Cycle Omics
CYCLoPs (Sam3-GFP)
| Gene / Allele | Actin Patch (Sac6-tdTomato) | Cortical Patch (Sla1-GFP) | Late Endosome (Snf7-GFP) | Vacuole (Sac6-tdTomato) |
|---|
| Gene | Images |
|---|
| Gene | Images |
|---|
Images are not yet available
Images are not yet available